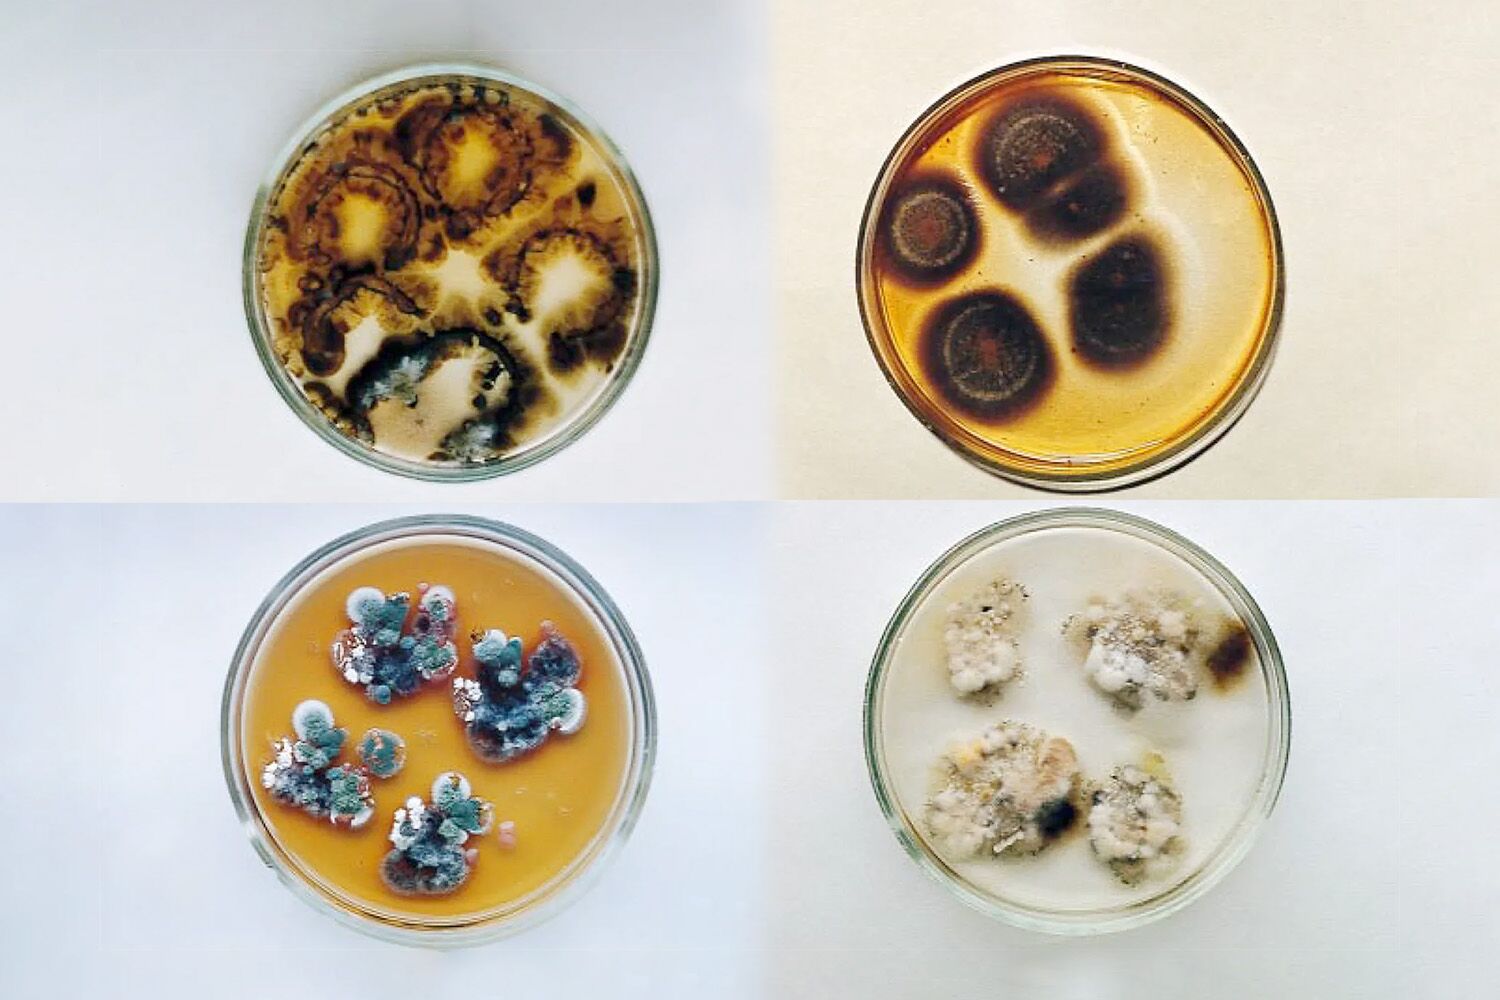
The mystery of the strange black fungus from Chernobyl that survives — and performs “photosynthesis”

Zhdanova et al. /Elsevier

Cultures found in Chernobyl’s fourth unit, including Cladosporium sphaerospermum. The upper right plate clearly shows melanization
When exposed to ionizing radiation that normally has catastrophic effects on other living organisms, the fungus is not only not damaged, it flourishes. The melanin that gives it its black color appears to play a role similar to chlorophyll in plant photosynthesis — a theoretical process called radiosynthesis.
The Chernobyl exclusion zone may be off-limits to humans, but since reactor four at the Chernobyl Nuclear Power Plant exploded almost 40 years ago, other life forms not only installedhow they survived, adapted and, apparently, prospered — as is the case with famous people.
Part of this prosperity may be due to absence of humans — but for at least one organism, the ionizing radiation that remains in the structures around the reactor could be an advantage.
It was precisely there, clinging to the interior walls of one of the most radioactive buildings on the planet, that scientists who, curiously, seem to be flourishing.
This fungus is called Cladosporium sphaerospermumand some researchers believe that its dark pigment — the melanin — could allow you to harness ionizing radiation through a process similar to what plants use to capture light in photosynthesis, explains .
This proposed mechanism is even called radiosynthesis.
Although scientists have demonstrated that the fungus thrives in the presence of ionizing radiation, no one has yet figured it out exactly how or why. Radiosynthesis is a theory, but difficult to prove.
The mystery dates back to the late 1990swhen a team led by the microbiologist Nelli Zhdanovafrom the National Academy of Sciences of Ukraine, carried out a field trip in the Chernobyl Exclusion Zone to discover What life forms, if any, were able to survive in the shelter around the destroyed reactor.
The team was surprised to find a true fungal communityhaving recorded no less than 37 species. Notably, these organisms tended to be dark or black, rich in melanin.
O C. sphaerospermum dominated the samplesalso presenting some of the highest levels of radioactive contamination. As surprising as the discovery was, what followed was increase the intrigue even further.
In 2007, the radiopharmacologist Ekaterina Dadachova and immunologist Arturo Casadevall, from the Albert Einstein College of Medicine, in the USA, led a team of researchers who exposing C. sphaerospermum to radiation ionizing does not affect the fungusas would happen with other organisms.
Ionizing radiation refers to the emission of particles energetic enough to rip electrons from their atomstransforming them into ions.
This may seem harmless on paper, but in practice ionization can destroy molecules, interfere with biochemical reactions and until the DNA is fragmented. None of this is good for humans, although it may be useful for destroying cancer cellswhich are particularly sensitive to these effects.
However, the C. sphaerospermum demonstrated a runusual resistance and even grew better when exposed to ionizing radiation. Other experiments have shown that ionizing radiation altered the behavior of the fungus’ melanin — an intriguing observation that warranted further investigation.
In a published in 2008 in Current Opinion in MicrobiologyDadachova and Casadevall proposed for the first time the idea that a biological pathway similar to photosynthesis.
The fungus — and other organisms like it — appeared to be capturing ionizing radiation and convert it into energyin a process in which melanin has a similar to the pigment chlorophyll of plants in light absorption.
At the same time, melanin acts as a protective shield against the most harmful effects of radiation.
This hypothesis gained strength with the conclusions of a published in 2022 in Frontiers in Microbiologyduring which a team of scientists took a sample of C. sphaerospermum into space, which was placed outside the International Space Station (ISS) and exposed to cosmic radiation.
In the experiment, sensors placed under the Petri dish showed that there had been a lower amount of radiation passing through the fungicompared to the control box that contained only agar.
To date, however, scientists failed to demonstrate fixation non-carbon C. sphaerospermum dependent on ionizing radiation, any metabolic gains from this radiation, or even an energetic path well defined.
“In reality, radiosynthesis has not yet been provenlet alone the reduction of carbon compounds to forms with higher energy content or the fixation of inorganic carbon driven by ionizing radiation”, he writes Nils Averescha researcher at Stanford University, in the 2022 study.
The idea of radiosynthesis is fascinating — sounds like something out of a science fiction novel. But perhaps even more impressive is the fact that this peculiar fungus is making something we still don’t understandmanaging to neutralize such a deadly danger to humans.
The behavior observed in the C. sphaerospermum is not universal among melanized fungi, which suggests that it may it is an adaptation which allows the fungus to harness a form of energy that is lethal to other organisms.
Or will it be just a stress responsewhich increases survival in extreme but far from ideal conditions? At this point, it is impossible to have an answer.
What we do know is that this discreet, velvety black fungus is ingeniously using ionizing radiation to survive — and maybe even thrive — in a place too dangerous for human presence. Life, in fact, always finds a way.